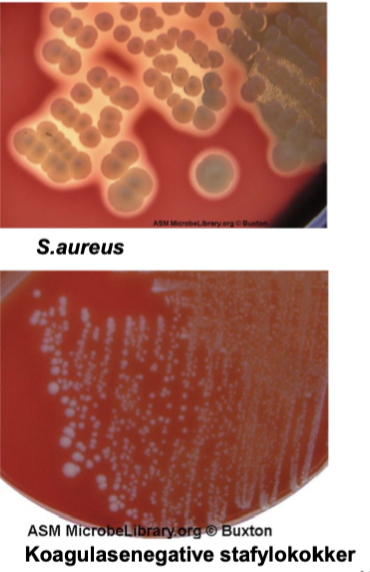

Hva slags type organisme er bakterier?
Prokaryote organismer som er unicellulære og som ikke har nuklær membran, mitokondrier, Golgilegeme og endoplasmatisk retikulum, og de reproduserer seg aseksuelt.
Hvordan kan man skille mellom ulike typer bakterier?
Ved hjelp av Gram-farging.
- Gram-positiv celle har en vegg som inneholder et tykt lag med peptidoglykan = lilla/blå
- Gram-negativ celle har en cegg som inneholder et tynt lag med peptidoglykan = rosa/rød
På hvilken måte kan man klassifiserer ulike bakterier?
Ved hjelp av:
- Gram-farging
- Størrelsen (1 til 20 mikrometer)
- Form (sfærer [kokker], staver og spiraler)
- Spatial arrangering (encellet, par, kjeder eller kløster)
- Aerobisk (trenger oksygen), anaerobisk (trenger ikke okysgen) eller fakulative anaerober (kan leve i både med og uten oksygen).
Hva er viktig ved en infeksjon?
Sammenhengen mellom klinikken og den bakterien man mistenker.
Hvilken type gramfarging og utseende har disse bakteriene?
1. Staphylococcus aureus
2. Streptococcus pyogenes (GAS)
3. Eshceria coli
4. Streptococcus pneumoniae
5. Neisseria meningitidis
6. Haemophilus influenza
- Grampositiv kokker i hauger
- Grampositive kokker i kjeder
- Gramnegative staver
- Grampositive diplokokker
- Gramnegative diplokokker
- Gramnegative (små) staver
Hva slags typisk klinisk bildet gir disse bakteriene ved infeksjon?
1. S.aureus
2. S.pyogenes
3. E.coli
4. S.pneumoniae
5. Neisseria meningtidis
6. Haemophilus influenza
- Bulløs impetigo (brennkopper)
- Nekrotiserende fascitt og akutt tonsilitt
- Urinveisinfeksjoner
- Øvre og nedre luftveisinfeksjoner
- Meningitt
- Luftveisinfeksjoner og meningitt
Hva er spesielt med McConkey agar?
Selektiv for Enterobacterales p.g.a. gallesalter som hemmer vekst av gram-positive bakterier.
Hva er spesielt med Gentiana Violett (GV) agar?
Her skal ikke stafylokokker vokse og beta-hemolytiske streptokokker skal få hemolyse (beta-hemolyse)
Hva mener man med “ulik grad av patogenisitet?
Man skiller mellom bakterier som ikke er farlige for mennesker, bakterier som er i mikrobiomet, humanpatogene og høypatogene bakterier.

Hvorfor er enkelte bakterier patogene for mennesker?
- Evnen til å passere kroppens smittebarrier (evt. bakterier som er tilstede når en barriere brytes)
- Evnen til å kolonisere, adhere, invadere
- Evnen til å forårsake vevsdestruksjon
- Evnen til å danne toksiner; endo- og eksotoksiner, superantigener
- Evnen til å forårsake inflammasjon
- Evne til å unngå vertens forsvarsmekanismer
Nevn noen av de viktigste bakteriene som danner infeksjoner i kroppen og hvor de gjør dette.

Hvilke bakterier er en del av vår normalflora, og hvor sitter de?

Gi en svært forenkelt (gramfarging) oversikt over humanpatogene bakterier.
Gram-positive bakterier:
- Stafylokokker
- Streptokokker (inkl. pneumokokker)
- Enterokokker
- Listeria
Gram-negative bakterier:
- Enterobakterier
- Neisseria
- Haemophilus
- Pseudomonas
Hva er de viktigste forskjellene mellom kapselen mellom de gram-positive og de gram-negative bakteriene?
Gram-positive:
- Peptidoglykan lag.
Gram-negativ:
- Lipopolysakkarid (LPS) eller endotoksin

Hvilke arter er viktigs når det gjelder stafylokokker?
Staphylococcus aureus
- Viktigste humanpatogene stafylokokk
- Normalflora på slimhinner/hud (20-50%)
- = “gule stafylokokker
Koagulasenegative stafylokokker (KNS)
- Normalflora på hud hos alle
- Forårsaker særlig infeksjon ved å danne biofilm på fremmede implantater/kateter etc…
- Flere arter der s.epidermidis og s.saprophyticus er de viktigste humanpatogene
- =”hvite stafylokokker
Hvordan vil en stafylokokkbakterie arte seg på blodagar?
- S.aureus vil ha store, glatte (“smooth) kolonier med (kan ha) gult pigment og kan ha B-hemolyse
- KNS vil ofte ha mindre kolonier og hvitt-grått pigment
Hvordan skiller mans.aureus fra andre stafylokokker?
- Koagulasetest –> positiv
- Massespektrometri (MALDI-TOF MS)
Hvilke type sykdomsmanifestasjoner (overflatiske) gir s.aureus?
- Impetigo (brennkopper): pussfylte vesikler, bulløs vs. ikke-bulløs (ektyma, kruster)
- Follikulitt: infeksjon i hårsekk
- Furunkel: øm abscess i hud eller underhud, ofte utgående fra folikulitt
- Karbunkel: Større enn furunkel, resultat av at multiple karbunkler har smeltet sammen
- Sårinfeksjoner
Hvilke dypere infeksjoner kan skyldes s.aureus?
Gir pyogene hudinfeksjoner
- Celluitt (og erysipelas [rosen]): bakteriell infeksjon i hud og underhud
- Abscess: pussfylt hulrom, som og kan dannes i dypt vev/dype organer (psoasabscess, abscess i ryggvirvel)
Hvilke systemiske sykdomsmanifestasjoner kan s.aureus gi?
- Endokarditt
- Osteomyelitt
- Spondylodiskitt
- Artritt
- Sepsis
- Empyem
- Pneumoni
- UVI
Hvilke toksinmedierte manifestasjoner kan s.aureus gi?
- Hud: Staphylococcal scalded skin syndrome (SSSS)
- Gastrointestinale: Matforgiftning
- Systemiske: Toksis sjokk syndrom (TSS)
Hvilke virulensfaktorer har stafylokokker?

Hvilke sykdomsmanifestasjoner har KNS?
Fremmedlegemeinfeksjoner (biofilm)
- Endokarditt
- Kateter-, shunt-, proteseinfeksjoner
S.epididermidis er vanligst
- Økende sepsis hos immunsupprimerte
Urinveisinfeksjon: S.saprophyticus –> hos yngre kvinner
Hva er biofilm?
Er stoffer som bakteriene skille ut for deretter å danne et matrix som de kan gjemme seg i.
- Gjør det vanskelig for A.B. å trenge inn til bakterien
- Setter seg på fremmede objekter (f.eks. kateter, proteser etc.).










